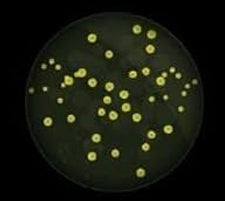

Last van stof, pollen of muffe lucht in huis?
Onze luchtreinigers filteren de lucht continu en helpen allergenen, bacteriën en vervuiling drastisch te verminderen. Zo creëer je een frissere, gezondere leefomgeving voor jou en je gezin.
Kies voor comfort, gezondheid en rust in huis, kies voor Erikssøn
Schone lucht betekent direct een voelbaar gezondere leefomgeving. Met een Erikssøn luchtreiniger worden vervuilende deeltjes zoals fijnstof, pollen, rook, bacteriën en huidschilfers effectief uit de lucht gefilterd.